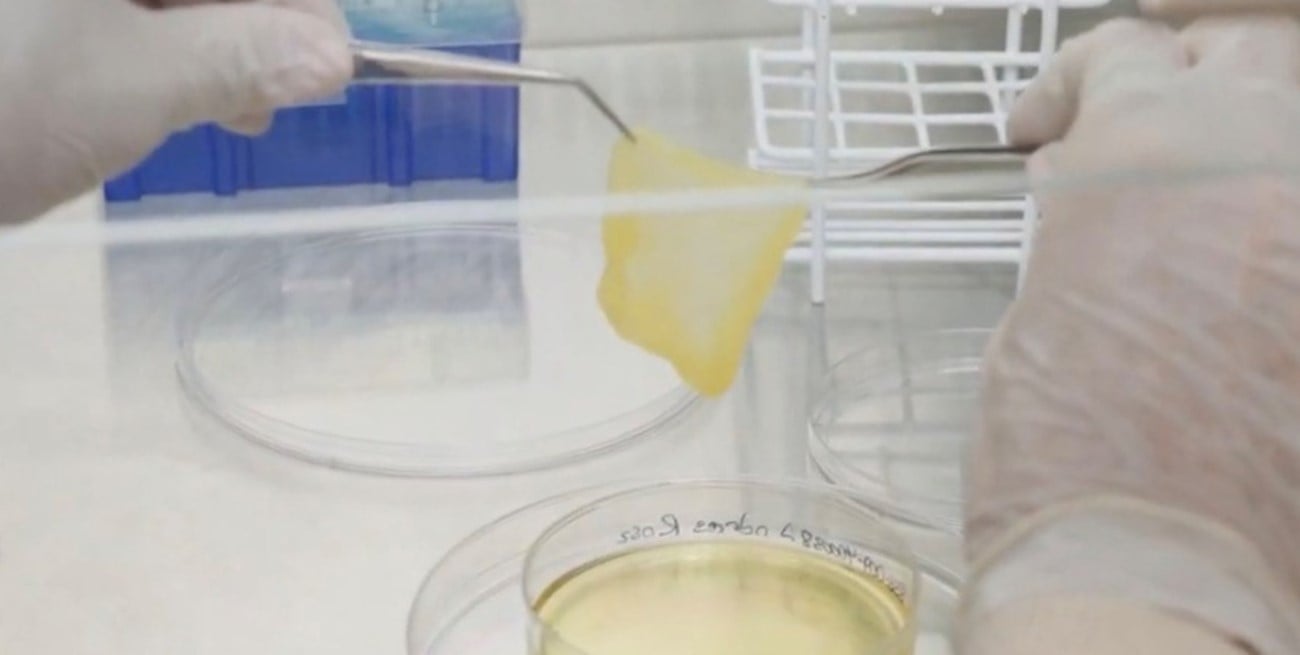
Una técnica argentina ayudó a recuperar la piel propia de un paciente después de quemaduras severas

El Hospital Italiano de Buenos Aires logró un avance destacado en bioingeniería de tejidos: desarrolló una técnica para cultivar piel a partir de células del propio paciente y aplicarla luego en zonas severamente quemadas o con heridas difíciles de cicatrizar.